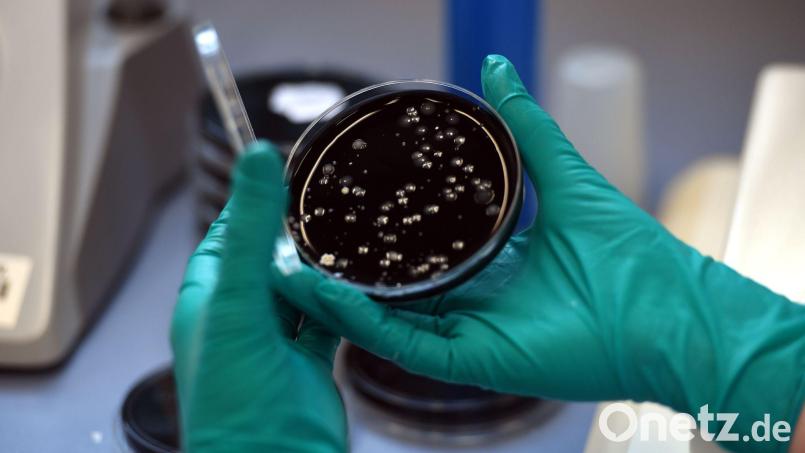
Nach einem Legionellen-Ausbruch in Ulm sind zwei Menschen gestorben. (Symbolbild) Bild: picture alliance / dpa

Nach einem Legionellen-Ausbruch mit zwei Toten in einem Ulmer Fußpflegesalon hat die Staatsanwaltschaft die Ermittlungen eingestellt. Ein strafbares Fehlverhalten der Betreiberin konnte nicht nachgewiesen werden, wie die Anklagebehörde auf Anfrage mitteilte. Das Verfahren wegen fahrlässiger Tötung in zwei Fällen sowie fahrlässiger Körperverletzung in 21 Fällen sei mangels Tatnachweises eingestellt worden. Zuvor hatte die „Südwest Presse“ darüber berichtet.
Die Beschuldigte stand im Verdacht, bei mehreren Behandlungen mit verunreinigtem Wasser gearbeitet zu haben. Insgesamt 21 Menschen infizierten sich laut Ermittlungen zwischen Dezember 2024 und Januar 2025 mit Legionellen, zwei von ihnen starben später, wie nun bekannt wurde. Als mögliche Quelle galt eine Fußwanne an einem Behandlungsstuhl.
Behandlungsstuhl aus dem Verkehr gezogen
Im Zuge der Untersuchungen ergaben sich jedoch keine Hinweise auf Verstöße gegen Hygienevorschriften oder Sorgfaltspflichten, so die Staatsanwaltschaft weiter. „Ihr konnte auch nicht nachgewiesen werden, dass sie das fragliche Fußbecken nicht fachgerecht gereinigt hätte.“ Die Bildung der Legionellen sei für die Betreiberin nicht erkennbar gewesen und zunächst unentdeckt geblieben. Auch eine Pflicht, die Wasserqualität regelmäßig eigenständig zu überprüfen, habe nicht bestanden.
Nach Bekanntwerden des Ausbruchs wurde der betroffene Behandlungsstuhl demnach vom Gesundheitsamt stillgelegt. Das Fußbecken war zu diesem Zeitpunkt laut Staatsanwaltschaft allerdings schon entsorgt worden, sodass eine nachträgliche detaillierte Untersuchung nicht mehr möglich war. Weitere Kontrollen im Salon brachten keine Auffälligkeiten zutage.
Was sind Legionellen?
Legionellen sind weltweit verbreitet und gedeihen in warmem Süßwasser. Sie können durch zerstäubtes Wasser eingeatmet werden, Infektionsquellen sind oft Duschen, Klimaanlagen oder Whirlpools. Eine Infektion mit diesen Bakterien kann symptomlos bleiben, aber auch grippeartige Symptome oder die Legionärskrankheit auslösen. Betroffen sind vor allem abwehrgeschwächte Erwachsene.
© dpa-infocom, dpa:260414-930-943307/1

Um Kommentare verfassen zu können, müssen Sie sich anmelden.
Bitte beachten Sie unsere Nutzungsregeln.